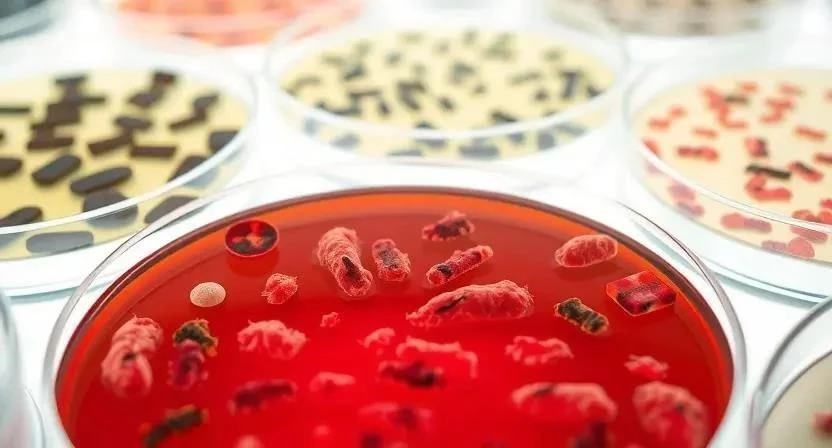

Задумывались ли вы о том, насколько опасна больница может быть для здоровья? Несмотря на то, что мы идем в больницу, чтобы получить помощь, существует риск заразиться внутрибольничной инфекцией. По статистике, до 2,5 миллионов россиян ежегодно сталкиваются с этой проблемой. Бактериальные инфекции, приобретенные в стационарах, представляют серьезную угрозу для пациентов, увеличивая сроки госпитализации и повышая затраты на лечение.
Определение и классификация
Бактериальные инфекции в больницах, также известные как внутрибольничные или госпитальные инфекции (ИСМП), – это инфекционные процессы, которые развиваются у пациентов во время пребывания в медицинском учреждении или после выписки, если они связаны с оказанием медицинской помощи. Эти инфекции могут быть вызваны различными бактериями, вирусами или грибками, и часто отличаются от тех, которые встречаются в обществе. Они классифицируются по месту возникновения (например, инфекции мочевыводящих путей, пневмонии, хирургические инфекции) и типу возбудителя.
Статистика заболеваемости
В России статистика заболеваемости ИСМП вызывает серьезную обеспокоенность. По данным различных источников, ежегодно регистрируется от 50 до 60 тысяч случаев ИСМП, хотя эксперты считают, что реальные цифры значительно выше из-за недостаточной отчетности. В последние годы наблюдается рост заболеваемости некоторыми инфекциями, такими как коклюш (в 7,6 раза по сравнению со среднемноголетними показателями), корь (в семь раз) и вирусная внебольничная пневмония (в 5,6 раза). Ущерб от внутрибольничных инфекций в России оценивается в 300-500 млрд рублей ежегодно, а около 6 случаев ИСМП приводят к летальному исходу.
| Год | Количество случаев ИСМП |
|---|---|
| 2018 | 52 000 |
| 2019 | 55 000 |
| 2020 | 58 000 |
| 2021 | 60 000 |
| 2022 | 62 000 |
Факторы риска
Распространение инфекций в больницах обусловлено множеством факторов. Сюда относятся: высокая концентрация восприимчивых пациентов, наличие инвазивных процедур (например, хирургические операции, катетеризация), несоблюдение правил гигиены медицинским персоналом, недостаточная дезинфекция и стерилизация оборудования, антибиотикорезистентность бактерий, переполненность палат и недостаточная вентиляция. Важно понимать, что даже незначительное нарушение санитарных норм может привести к серьезным последствиям.
| Фактор риска | Описание |
|---|---|
| Инвазивные процедуры | Хирургические операции, катетеризация, искусственная вентиляция легких |
| Несоблюдение гигиены | Недостаточное мытье рук, отсутствие использования перчаток и масок |
| Антибиотикорезистентность | Устойчивость бактерий к антибиотикам |
| Переполненность палат | Увеличение риска перекрестного заражения |
| Недостаточная дезинфекция | Неэффективная обработка поверхностей и оборудования |
Последствия ИСМП
Внутрибольничные инфекции оказывают значительное негативное влияние на здоровье пациентов. Они могут приводить к увеличению сроков госпитализации, развитию осложнений, повышению риска летального исхода и увеличению затрат на лечение. Кроме того, ИСМП могут ухудшить качество жизни пациентов и привести к инвалидности. Я помню случай, когда у моего знакомого после операции развилась инфекция, и ему потребовалось дополнительное лечение в течение нескольких месяцев.
Методы профилактики
Профилактика ИСМП – это комплекс мер, направленных на предотвращение распространения инфекций в больницах. К ним относятся: соблюдение правил гигиены медицинским персоналом (мытье рук, использование перчаток и масок), эффективная дезинфекция и стерилизация оборудования, рациональное использование антибиотиков, изоляция инфицированных пациентов, вакцинация медицинского персонала и пациентов, мониторинг и анализ данных о заболеваемости. Важно, чтобы все сотрудники больницы были вовлечены в процесс профилактики.
- Регулярное мытье рук с мылом и водой или использование антисептиков.
- Использование перчаток и масок при контакте с пациентами и биологическими жидкостями.
- Тщательная дезинфекция и стерилизация медицинского оборудования.
- Рациональное использование антибиотиков для предотвращения развития резистентности.
- Изоляция пациентов с инфекционными заболеваниями.
- Вакцинация медицинского персонала и пациентов.
- Регулярный мониторинг и анализ данных о заболеваемости.

Дезинфекция и стерилизация
Дезинфекция и стерилизация играют ключевую роль в контроле инфекций в больницах. Дезинфекция – это процесс уничтожения большинства патогенных микроорганизмов на поверхностях и оборудовании. Стерилизация – это более радикальный процесс, который уничтожает все микроорганизмы, включая споры. Выбор дезинфицирующего средства зависит от типа поверхности и предполагаемого уровня загрязнения. Я всегда обращаю внимание на то, чтобы в больницах, где я бываю, проводилась регулярная и качественная дезинфекция.
| Дезинфицирующее средство | Применение |
|---|---|
| Хлорсодержащие растворы | Дезинфекция поверхностей, инструментов |
| Спиртосодержащие растворы | Дезинфекция кожи рук, небольших поверхностей |
| Перекись водорода | Дезинфекция ран, инструментов |
| Четвертичные аммониевые соединения | Дезинфекция поверхностей, оборудования |
Антибиотикотерапия
Рациональное использование антибиотиков – важный аспект профилактики ИСМП. Необоснованное применение антибиотиков способствует развитию резистентности бактерий, что затрудняет лечение инфекций. Важно назначать антибиотики только при наличии показаний, выбирать наиболее эффективный препарат и соблюдать правильную дозировку и продолжительность лечения. Я считаю, что врачи должны быть очень осторожны при назначении антибиотиков, чтобы не усугубить проблему резистентности.
Контроль инфекций
Организация службы контроля инфекций в больнице – необходимое условие для эффективной профилактики ИСМП. Эта служба должна заниматься мониторингом и анализом данных о заболеваемости, разработкой и внедрением профилактических мер, обучением медицинского персонала и проведением эпидемиологических расследований. Важно, чтобы служба контроля инфекций имела достаточные ресурсы и полномочия для выполнения своих задач.
Современные технологии
В последние годы для борьбы с инфекциями в больницах используются новые технологии, такие как ультрафиолетовое облучение, автоматизированные системы дезинфекции, системы мониторинга гигиены рук и использование антимикробных покрытий. Эти технологии позволяют повысить эффективность профилактических мер и снизить риск распространения инфекций.
FAQ
- Что такое ИСМП? Внутрибольничные инфекции – это инфекции, приобретенные в медицинском учреждении.
- Как можно предотвратить ИСМП? Соблюдение правил гигиены, дезинфекция, рациональное использование антибиотиков.
- Какие последствия могут быть у ИСМП? Увеличение сроков госпитализации, осложнения, летальный исход.







